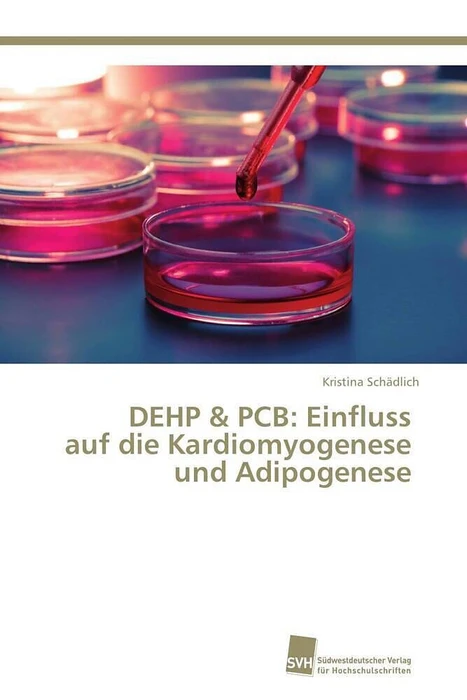

Wir verwenden Cookies und Analyse-Tools, um die Nutzerfreundlichkeit der Internet-Seite zu verbessern und für Marketingzwecke. Wenn Sie fortfahren, diese Seite zu verwenden, nehmen wir an, dass Sie damit einverstanden sind. Zur Datenschutzerklärung.
DEHP & PCB: Einfluss auf die Kardiomyogenese und Adipogenese
Details
"Is plastic really fantastic?" - ist eine der Fragen, welcher sich die heutige Gesellschaft stellen muss. Einer der Bestandteile der meisten Plastikprodukte des täglichen Gebrauchs ist der Weichmacher Di(2-ethylhexyl)phthalat (DEHP). Eine weitere große und nachweislich endokrin wirksame Gruppe von Umweltschadstoffen sind die polychlorierten Biphenyle (PCB). Beiden Schadstoffen, und mehreren tausend mehr, ist der Mensch in der industrialisierten Welt tagtäglich ausgesetzt. Parallel zum verstärkten Einsatz dieser Chemikalien stieg die Prävalenz von Zivilisationskrankheiten wie Herzkreislauferkrankungen, Adipositas und Diabetes Typ II während der letzten 30 Jahre drastisch an. Dabei stellt sich die Frage, inwiefern eine frühe DEHP/PCB-Exposition des Ungeborenen im Mutterleib bereits zur Weichenstellung in Richtung Herzkreislauferkrankungen und Metabolisches Syndrom im späteren Leben beiträgt. Diese Problematik fällt unter die "Developmental Origins of Health and Disease"-Hypothese von Prof. David Barker. Die vorliegende Studie verwendete murine in-vitro Zellkulturmodelle um mögliche Wirk-Mechanismen von DEHP und PCB in der Kardiomyogenese und Adipogenese zu identifizieren.
Autorentext
Dr. Kristina Schädlich studierte von 2003-2008 Biologie an der MLU Halle-Wittenberg. Ihre Promotion absolvierte Sie in der Arbeitsgruppe von Prof. Dr. Dr. Bernd Fischer am Institut für Anatomie und Zellbiologie der MLU Halle-Wittenberg. Derzeit ist Sie als Dozentin für Anatomie und weiterhin in der Forschung aktiv.
Klappentext
Is plastic really fantastic? ist eine der Fragen, welcher sich die heutige Gesellschaft stellen muss. Einer der Bestandteile der meisten Plastikprodukte des täglichen Gebrauchs ist der Weichmacher Di(2-ethylhexyl)phthalat (DEHP). Eine weitere große und nachweislich endokrin wirksame Gruppe von Umweltschadstoffen sind die polychlorierten Biphenyle (PCB). Beiden Schadstoffen, und mehreren tausend mehr, ist der Mensch in der industrialisierten Welt tagtäglich ausgesetzt. Parallel zum verstärkten Einsatz dieser Chemikalien stieg die Prävalenz von Zivilisationskrankheiten wie Herzkreislauferkrankungen, Adipositas und Diabetes Typ II während der letzten 30 Jahre drastisch an. Dabei stellt sich die Frage, inwiefern eine frühe DEHP/PCB-Exposition des Ungeborenen im Mutterleib bereits zur Weichenstellung in Richtung Herzkreislauferkrankungen und Metabolisches Syndrom im späteren Leben beiträgt. Diese Problematik fällt unter die Developmental Origins of Health and Disease -Hypothese von Prof. David Barker. Die vorliegende Studie verwendete murine in-vitro Zellkulturmodelle um mögliche Wirk-Mechanismen von DEHP und PCB in der Kardiomyogenese und Adipogenese zu identifizieren.
Weitere Informationen
- Allgemeine Informationen
- GTIN 09783838138077
- Sprache Deutsch
- Genre Weitere Biologie-Bücher
- Größe H220mm x B150mm x T14mm
- Jahr 2014
- EAN 9783838138077
- Format Kartonierter Einband
- ISBN 978-3-8381-3807-7
- Veröffentlichung 25.03.2014
- Titel DEHP & PCB: Einfluss auf die Kardiomyogenese und Adipogenese
- Autor Kristina Schädlich
- Gewicht 364g
- Herausgeber Südwestdeutscher Verlag für Hochschulschriften
- Anzahl Seiten 232